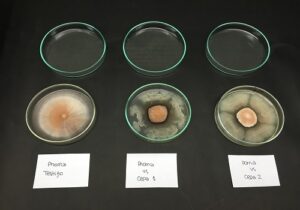

Se trata de organismos de vida libre, nativos y aislados por el INTA, en contacto con las raíces de los cultivos de cebolla, olivo y algodón. Mediante su acción antibiótica, protegen contra patógenos, al tiempo que favorecen su crecimiento y rendimiento.
Los hongos presentes en el suelo causan enfermedades que generan importantes pérdidas en la producción agrícola. Para controlar la sanidad, existen diversas estrategias entre las que se destacan el uso de variedades o híbridos resistentes, semillas certificadas, suelos libres de patógenos o su tratamiento mediante agentes físicos como el calor o químicos.
Este tema será parte de la agenda del 40.° Congreso Argentino de Horticultura, organizado por la Asociación Argentina de Horticultura (ASAHO) del 2 al 5 de octubre en Córdoba.
Para Daniel Ducasse –coordinador del Programa Nacional de Protección Vegetal del INTA–, existe una alternativa efectiva y sustentable para controlar los hongos patógenos habitantes de suelo a partir del uso de agentes de control biológico como las rizobacterias promotoras de crecimiento (PGPR, por sus siglas en inglés).
Se trata de bacterias –nativas y aisladas por el INTA– de vida libre que habitan la rizosfera, es decir, un volumen de suelo que está en íntimo contacto con las raíces.
“Estos organismos se caracterizan por favorecer el crecimiento de las plantas e incrementar su capacidad de defensa contra patógenos, ya sea por ejercer un control directo sobre éstos mediante una acción antibiótica, o bien por inducir mecanismos de defensa sistémicos en las plantas hospedantes”, detalló el técnico.
“Actualmente, contamos con cepas de Bacillus con excelente capacidad de control del hongo Setophoma terrestres, causante de la raíz rosada de la cebolla”, indicó Ducasse.
Además, ponderó el logro por tratarse de una alternativa eficaz a las convencionales prácticas de control que incluyen rotaciones de cultivo, uso de variedades de cebolla resistentes y hasta la aplicación de agroquímicos en el suelo. Mientras que esta última está contraindicada por su baja eficiencia y su alto impacto ambiental, las variedades resistentes disponibles en otras regiones del mundo no tienen un buen comportamiento en la Argentina.
A su vez, el patógeno tiene la capacidad de desarrollar estructuras de resistencia que le permiten persistir largos períodos en el suelo, condición que demanda regímenes de rotación muy prolongados que atentan contra la rentabilidad de los lotes.

En cuanto a la verticilosis del olivo, Ducasse destacó los avances en el biocontrol de esta enfermedad causada por el hongo Verticillium dahliae. Se trata de un patógeno que causa la muerte de la planta y, gracias a estructura de resistencia, perdura en el suelo. En este contexto, reponer una planta en el mismo lugar resulta prácticamente imposible.
“Recolectamos más de 1500 aislamientos de bacterias de suelo, de las cuales 200 fueron seleccionadas como potenciales agentes de biocontrol de V. dahliae”, aseguró el técnico, quien agregó: “Junto con investigadores del Conicet y de universidades nacionales evaluamos la resistencia, analizamos el inóculo en el suelo y estudiamos el biocontrol con hongos como Trichoderma, entre otros estudios”.
Si bien 15 se destacaron por su capacidad de inhibición de crecimiento del hongo, caracterizaron cinco en profundidad con potencial para inhibir la formación de microesclerocios. “Estamos en el proceso de probar las cepas en olivo directamente”, explicó.
En el cultivo de algodón, el equipo trabaja para obtener bacterias PGPRs nativas de la Argentina que puedan inhibir un complejo de patógenos de suelo entre los cuales, además de Verticillium dahliae, están Pythium y Rhizoctonia, hongos de suelo responsables de podredumbres en semilla y en plántulas a campo.
Fuente: INTA




































